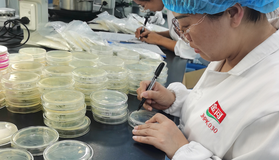

暂无搜索结果
-
1 项目一:走进微生物世界
-
1.1 任务1:撩开微生物的面纱
-
1.2 任务2:微生物“工厂”
-
1.3 实训1:玻璃器皿的准备
-
1.4 实训2:显微镜的使用
-
2 项目二:显微认识微生物
-
2.1 任务1:无处不在的“小精灵”—细菌
-
2.2 任务2:生产救命抗生素的贵人—放线菌
-
2.3 任务3:认识家养“宠物”—酵母
-
2.4 任务4:贪吃鬼—霉菌
-
2.5 任务5:走进病毒的“内心”
-
2.6 实训:油里看“小精灵”
-
3 项目三:悉心培养微生物
-
3.1 任务1:细胞营养及培养基的配制
-
3.2 任务2:蒸煮技术—培养基的消毒灭菌
-
3.3 任务3:倒平板—微生物分离培养
-
3.4 实训1:PDA培养基制备
-
3.5 实训3:接种技术
-
3.6 实训4:细菌的革兰式染色
-
4 项目四:认真监测微生物
-
4.1 任务1:微生物的生长测定
-
4.2 任务2:血球计数板的使用
-
4.3 实训1:果酒中酵母菌数量的计数
-
5 项目五:精心保藏微生物
-
5.1 任务1:菌种保藏
-
5.2 实训1:微生物简易保藏方法
-
6 项目六:检测应用微生物
-
6.1 任务1:微生物检测概述
-
6.2 任务2:花样酸奶的制作
-
6.3 实训1:菌落总数的检测
-
6.4 实训2:大肠菌群的检测
-
1
任务导读
-
2
知识点视频
-
3
任务测试
-
4
拓展

选择班级